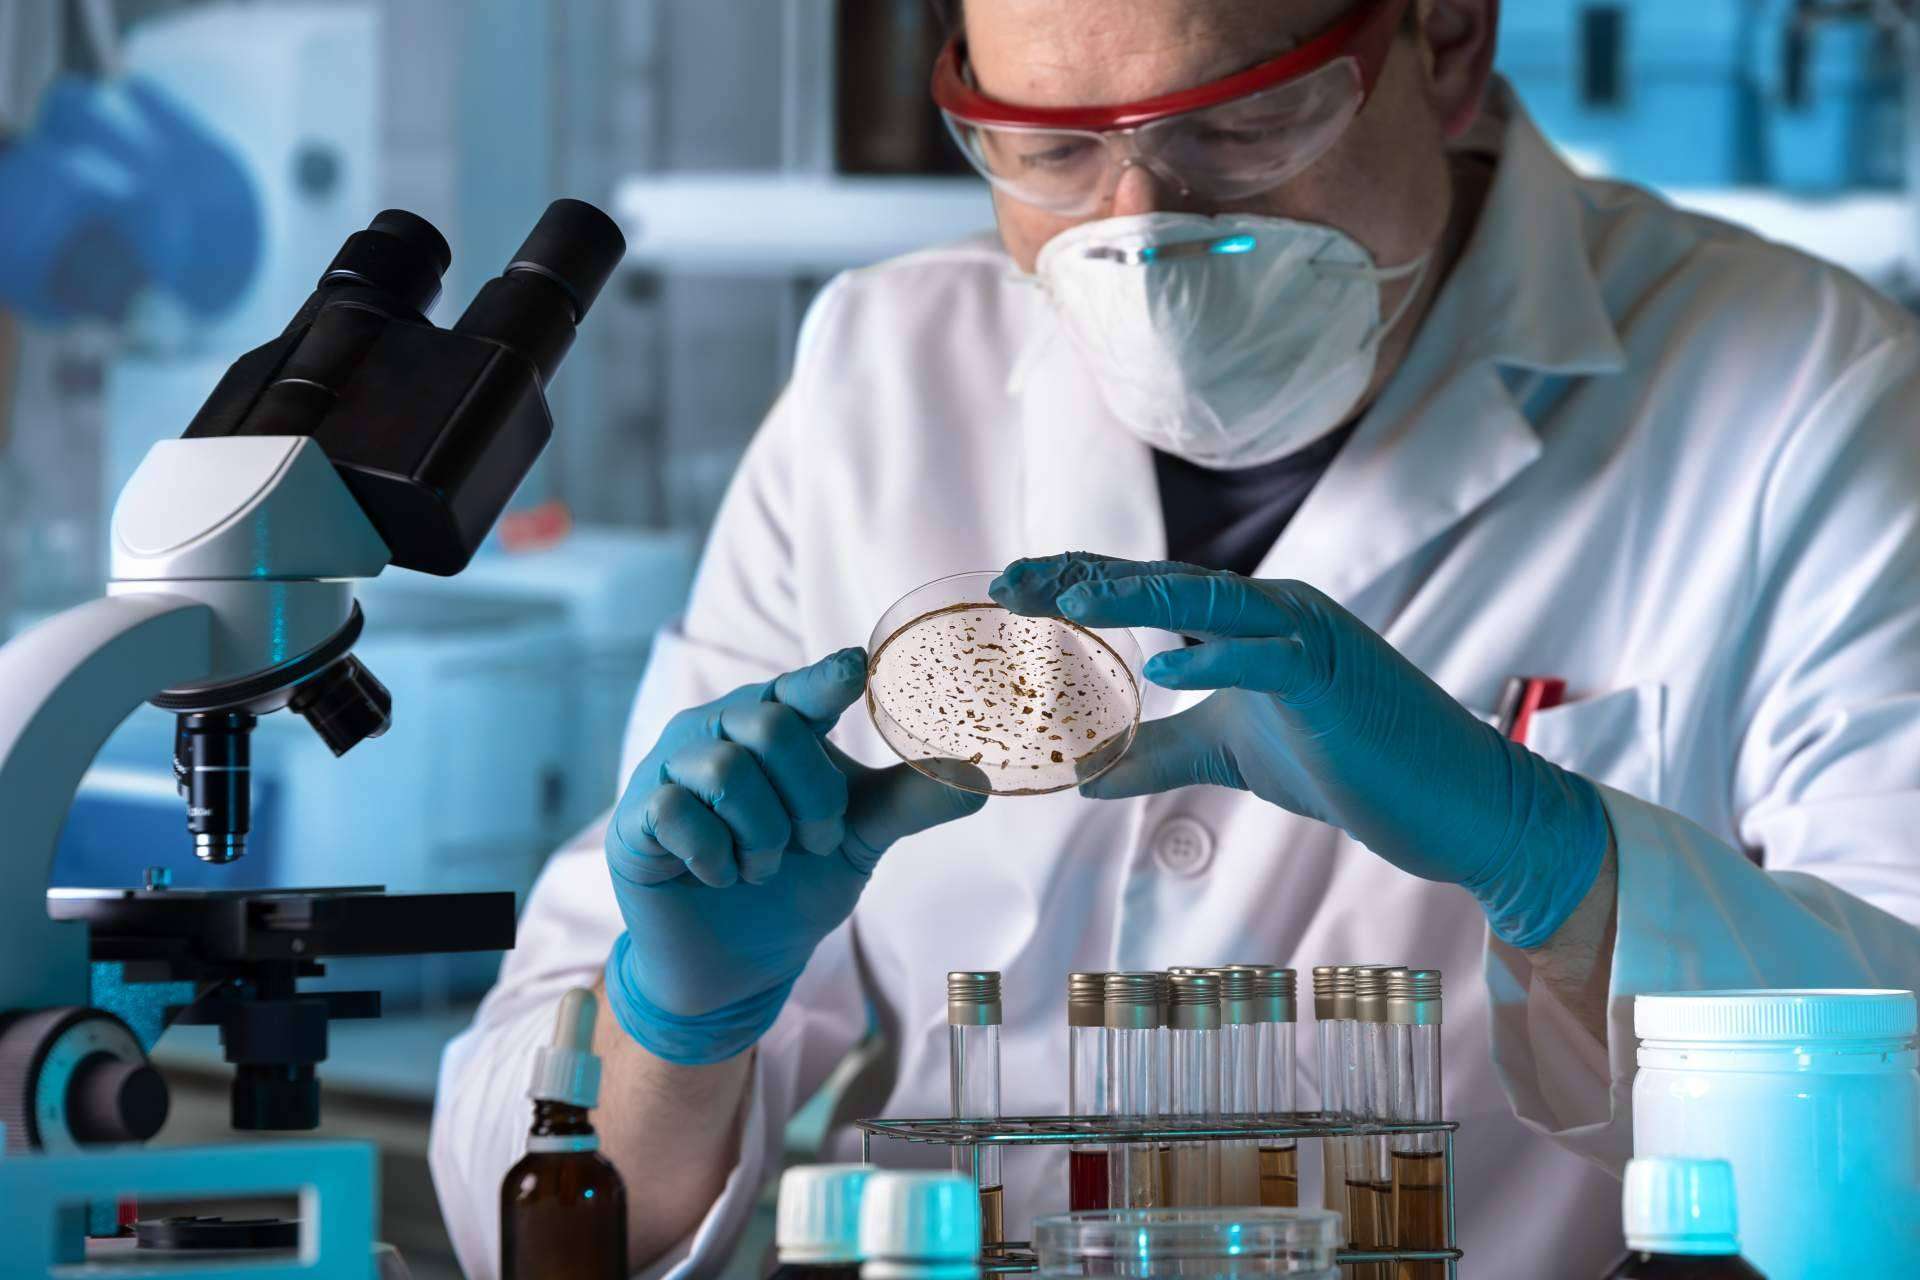

El equipo de regatas del RCN Arrecife (Lanzarote) se ha proclamado campeón de la semifinal de la Sailing Champions League Saint Petersburg Cup.
El único equipo español participante en el evento dio un verdadero espectáculo de buen navegar con acertadísimas maniobras y táctica.
Tras 18 mangas clasificatorias, el “Lanzarote European Sports Destination – Wacaf Air” pasaba líder a la final reservada para los 4 mejores equipos. Con tan solo ganar una manga de la final, se proclamaban campeones y eso fue lo que hicieron.
El pasado domingo terminó en aguas de San Petersburgo (Rusia) la semifinal de la Sailing Champions League, o lo que viene siendo la Liga Europea de Vela. El evento estuvo organizado de manera impecable por la Federación Rusa de Vela y el San Petersburg Yacht Club. Participaron un total de 17 equipos, de los cuales 14 eran rusos, un suizo, un alemán y un único español, los canarios del RCN de Arrecife “Lanzarote European Sports Destination – Wacaf Air” que fueron quienes se alzaron con el triunfo final de la cita europea
Ricardo Terrades da sus impresiones tras finalizar el campeonato: “Nos sentimos super felices. Llegar hasta Rusia desde España no fue nada fácil, pero el esfuerzo ha merecido la pena”. Sobre el sistema de competición, el project manager del equipo apunta que “la Sailing Champions League es una competición muy divertida y muy interesante. La rivalidad entre los equipos es máxima. La clasificación estuvo muy apretada, con muy pocos puntos de diferencia. Y aquí el mínimo error se paga muy caro, del mismo modo que una buena regata te da un respiro. En España ya competimos con el mismo sistema en la Liga Española de Vela – Trofeo Loterías y Apuestas del Estado y pienso que es un verdadero acierto”.
El triunfo de los españoles no fue ni mucho menos un camino de rosas. Primero tuvieron que aclimatarse a las duras condiciones de frío que esta semana hubo en el Mar Báltico navegando todos los días entre 5ºC y 8ºC y el agua a 10ºC. Después fue necesario adaptarse y conocer bien el barco en el que competían, el MX700 que a pesar de ser muy parecido al J70 (barco en el que ya navegan en España) guardaba sus diferencias. Por último, la propia competición en la que muchos equipos tenían claras opciones de ganar y con los que la guerra en el agua fue bastante dura. Regatas muy cortas, pero muy intensas que exigían estar siempre concentrados al 100% y sacarle al barco siempre el máximo rendimiento.
Competición en monotipos
Como es costumbre en la Liga Europea de Vela, se compite con monotipos. Es decir, todos los barcos son exactamente iguales y las embarcaciones se sortean entre los equipos participantes, que van rotando por los barcos que aporta la organización. De este modo, se busca premiar el talento y valía de las tripulaciones y no tanto apuesta a punto y guerra de material. En esta ocasión, el modelo elegido por la Federación Rusa de Vela ha sido el MX700, que tiene un diseño muy parecido al J70, con 7 metros de eslora, para 4 o 5 tripulantes y arbolado con mayor, foque y spinnaker asimétrico. El equipo español contaba con experiencia en navegar en este tipo de barco, ya que suele competir en los circuitos nacionales de J70 y J80.
Regata a regata, el triunfo final ha sido posible
En total se ha cumplido con todo el programa previsto, celebrándose un total de 36 mangas clasificatorias de las cuales cada equipo ha navegado en 18 ocasiones. De ahí, pasaban a la final solo los 4 equipos mejor clasificados. Quien ganara las regatas previas contaba ya con un primero en su casillero y los otros tres finalistas estaban a cero. Todos igualados, menos el líder que partía con un poco de ventaja. Para llevarse el triunfo final era necesario ganar dos regatas en la final. La emoción estaba servida.
El equipo liderado por Nano Negrín, “Lanzarote European Sports Destination – Wacaf Air”, salía al agua el último día en segunda posición de la clasificación general y a tan solo un punto del líder “Lord of Sail – Windy Girls” de Rusia, pero seguido muy de cerca de los suizos “Bondesee Yachclub Uberlingen” a tan solo un punto, a dos puntos de los rusos del “Tenzor Sport”, a tres puntos de “Calypso” también rusos y a cuatro puntos de los alemanes del “Regatta Club Oberhofen”. Los seis primeros clasificados estaban en un pañuelo cada uno a un punto del siguiente. Y aún, cada equipo debía regatear dos mangas clasificatorias más antes de la final.
En la primera regata del día los canarios del “Lanzarote European Sports Destination – Wacaf Air” hacían una salida impecable y se mantenían en cabeza toda la manga, pero en los últimos metros de la empopada final eran sobrepasados por dos embarcaciones, relegándose a la tercera posición. Quien ganó esa manga fue el líder “Lord of Sail – Windy Girls” con lo que conseguía aumentar su ventaja en 2 puntos más respecto a los de Lanzarote. En la siguiente prueba, el equipo español descansaba y seguía bien de cerca la competición, viendo como la victoria era para los suizos del “Bondesee Yachclub Uberlingen”, mientras que el líder ruso hacía un 5º. La clasificación se volvía a apretar de manera emocionantísima.
En la última prueba clasificatoria los de “Lanzarote European Sports Destination – Wacaf Air” se colocaron en cabeza gracias a una soberbia salida de su patrón Nano Negrín. Poco a poco, fueron superando a sus rivales, llegando a la primera baliza de barlovento muy cerca de los rusos “Tenzor Sport”, pero gracias a una hábil maniobra los españoles que eran barco de sotavento protestaron a los rusos y el árbitro les sacó bandera roja al “Tanzor Sport”, teniéndose ellos que penalizar. Los españoles ya se habían quitado a un duro rival de encima, siguieron navegando con tranquilidad y una buena táctica permitiéndoles ganar la última regata clasificatoria y pasar como líderes a la gran final.
Toda la emoción estaba en la gran final
La final estaba reservada para los 4 mejores, “Lanzarote European Sports Destination – Wacaf Air” en primer lugar, seguido del ruso “Lord of Sail – Windy Girls”, los suizos del “Bondesee Yachclub Uberlingen” y los alemanes del “Regatta Club Oberhofen”. Los canarios partían ya con una victoria parcial y quien consiguiera dos victorias se proclamaba campeón. En la final, los de Lanzarote volvieron a hacer una impecable salida por sotavento, mientras que los alemanes lo hacían por barlovento. Tras una apretadísima primera ceñida en la que ambos equipos estuvieron muy atentos a los roles, los alemanes cruzaban por la proa de los españoles amurados a estribor y estos se veían obligados a pasarles por la popa. En ese momento, los alemanes viraron a babor para marcar a los españoles y estos intentaron forzar una penalización orzándoles desde sotavento. Pero, en esta ocasión, el árbitro internacional sacaba bandera roja a los españoles, que se tuvieron que penalizar y perder sus opciones de triunfo, finalizando en tercera plaza en esa regata.
En la siguiente regata de la final, el equipo de Nano Negrín, Ricardo Terrades, Rafa Lasso y Gonzalo Morales hacía una mala salida y condicionándose para toda la regata. Los líderes de esta manga fueron claramente los suizos, quienes tenían controlados a sus rivales hasta la última empopada. Ahí fue cuando los de Lanzarote prolongaron por la derecha esperando nuevas presiones de viento. Suizos y alemanes optaban por tras luchar e ir a la izquierda. Al cabo de pocos minutos, la presión entró por la derecha beneficiando a los españoles y al ruso “Lord of Sail”. Españoles y rusos empezaron a navegar en modo alto, con foque desplegado y spinnaker a mucha más velocidad que sus contrincantes hasta que finalmente cruzaron la línea de llegada en primera posición y así se convirtieron en los campeones de esta disputadísima Sailing Champions League Sant Petersburg Cup.
El equipo de Lanzarote continúa regateando al máximo nivel
La victoria en San Petersburgo daba la posibilidad de participar en la gran final europea que se disputará en Porto Cervo (Italia), cita a la que los canarios del “Lanzarote European Sports Destination – Wacaf Air” no fallarán. A nivel nacional, el mismo equipo, aunque con otros tripulantes, seguirá compitiendo en la Liga Española de Vela – Trofeo Loterías y Apuestas del Estado. Tras un primer evento celebrado en El Arenal (Mallorca) los del RCN Arrecife – Lanzarote lideran la clasificación con más de 20 puntos de ventaja y deberán volver a navegar durante este mes de octubre en aguas de Calpe a bordo de los Tom 28 Max y optar nuevamente al título de campeón de la Liga Española de Vela 2021. Triunfo que ya consiguieron en 2019, mientras que en 2020 fueron subcampeones.